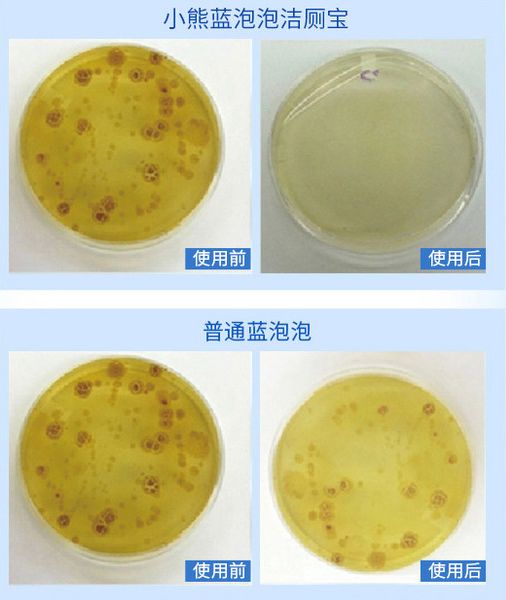
马桶自动清洁推荐,强力除臭抑菌马桶清洁剂

俗话说“人有三急”,很多人说想象不出自己偶像上厕所的样子。神仙姐姐都是喝露水长大的,才不需要拉屎呢,哼~

不,不管你想不想承认,她们也是要每天蹲马桶的,就和我们这些“凡人”一样。
根据世界厕所组织WTO(此WTO非彼WTO)提出的数据,每个人每天上厕所的次数为6-8次,一年为2500次,算下来人的一生大约有3年的时间是在卫生间中度过的。

然而,很多人家里的马桶环境是堪忧的。这种脏是看不见的,就算你觉得马桶看上去特别干净,但是在肉眼无法达到的显微镜级别,“冲干净”的马桶上面,细菌附着也达到了10万以上的量级!

这些细菌在马桶上的附着时间有些甚至可以达到17天。有些细菌在冲水时,还能被水的气流带入到几米的空中,悬浮在卫生间空气中长达几小时。

常见的有大肠杆菌、痢疾杆菌和金黄色葡萄球菌,他们一旦在你的身体里横行,很有可能引发腹泻、发热、呕吐等急性症状。
所以保持马桶的卫生是非常重要的。不管是明处的污垢,臭气,还是看不见的病菌,都是我们需要消灭的对象。

当有些人还在用长柄刷和洁厕液跟马桶做斗争时,有些家庭和比较高级一点的场所,却早已经升级了。
细心一点就会发现,他们有个相同特点,就是马桶里冲出来的水是蓝色的。

这种蓝色的水不仅能去除臭味,而且还有很好的杀菌除垢效果。
它有一个好听的名字,叫“蓝泡泡”。因其使用时会出现蓝色泡泡而得名,本质上是一种洁厕剂。

蓝泡泡在以前是很受欢迎的,毕竟不用人动手,马桶就可以一直保持干净清新的状态。
但是之后呢,还是会发现这种蓝色小块在使用中的不便利。不是水溶性包装的吧,你撕开的时候很容易掉色,将颜色沾染到手上。水溶性包装的有很容易受潮变质,不好储存。

而且它的使用时间太短了,基本5-10天的样子有得重新换新的,比较麻烦。你得囤很多在家里,还占地方。
今天小编就来解决你这些问题,它既有非常好的杀菌除臭效果,而且是块状蓝泡泡10倍的使用时长。
小熊蓝泡泡洁厕宝

你别看它萌萌的一个,它属于小小的身躯大大的容量,一个就可以抵10多个蓝泡泡了。
升级版活性因子
小熊蓝泡泡采用的是植物中萃取的表面活性剂,具有很强的去污能力,每次一冲都相当于清洁了一次马桶。

一直使用的话,完全不用担心马桶结垢,什么长柄刷和除垢剂都可以扔掉了。
而且植物表活是非常温和的,不会伤害马桶的水箱和釉面。放心吧,小熊安全得很,不会“碰瓷”的。

长期使用,甚至还能帮你把水箱里的水垢污渍消除干净呢~
自带清香 臭味不存在的
上厕所首先无法忍受的就是臭味了,平常自来水冲后,依旧会有臭味飘出。

但是有了小熊就不一样了,它是自带果香的,是一种很好闻的清香,冲水一次除一次臭,卫生间的异味,很轻松的就解决啦。
72小时长效抑菌
小熊蓝泡泡里面有一种特别的植物酸除菌剂,能够长期抑制细菌滋生,有效时间达72小时。
对于马桶中易于导致腹泻的大肠杆菌、金黄色葡萄球菌都有很好的抑菌效果。
同时对容易引起*处私**炎症的白色念球菌的抑制率也达到99%。
微孔缓释 耐用100天
相比于传统的蓝泡泡 10天的样子就要更换,小熊的使用时常直接延长了10倍!

它采用的是浓缩凝胶技术,能够长期稳定的缓缓释出,更加的耐用,普通家庭用3个月完全OK

丢进去一次,轻松3个月,再也不用隔几天就开一次水箱了。
不脏手 无残留
虽然它是植物色素提取,很安全。不过你也不需要接触到它,因为你只需要直接接触到瓶身而已,所以完全不用担心脏手哦。

普通的蓝泡泡,由于并不能很均匀的释放,所以有些会散开,冲水的时候可能会残留在马桶上。

但小熊的蓝泡泡一直都很稳定释放,第一次冲水到最后一次冲水的颜色几乎相差无几,不会 残留在马桶上,需要人工清除的情况。

简单一放 解决困扰
使用超简单的,只需要将小熊头顶的封纸和小塞子打开,然后竖直放到马桶水箱内即可。

然后让它安静的释放大概5-10分钟,就可以冲水啦。

如果10分钟内没释放,建议把它平躺放置。
注意事项
1.不要与84消毒液同时使用,会释放有毒氯气,对人体有害!
2.放到儿童接触不到的地方。
3.如果不小心进入眼睛,请勿揉搓,马上用大量清水清洗并且立即就医。
超多好评der~

大家之前都是买的圆形的,用完小熊蓝泡泡之后,都觉得很惊喜,比那种好用多了。
所以大家也一起买买买吧
入手不亏哦!
猜你喜欢

他家周末没人出门,三代人全在客厅玩耍,日子过得乐开花儿

超省钱装修法,50块的地板、20块的墙砖,看完效果我哭了!
商务合作
微信ID:TrendsZaijia006
微信ID:TrendsZaijia010
后台回复“转载”,获取转载须知
↓↓点击 阅读原文 ,即可进入微店 !